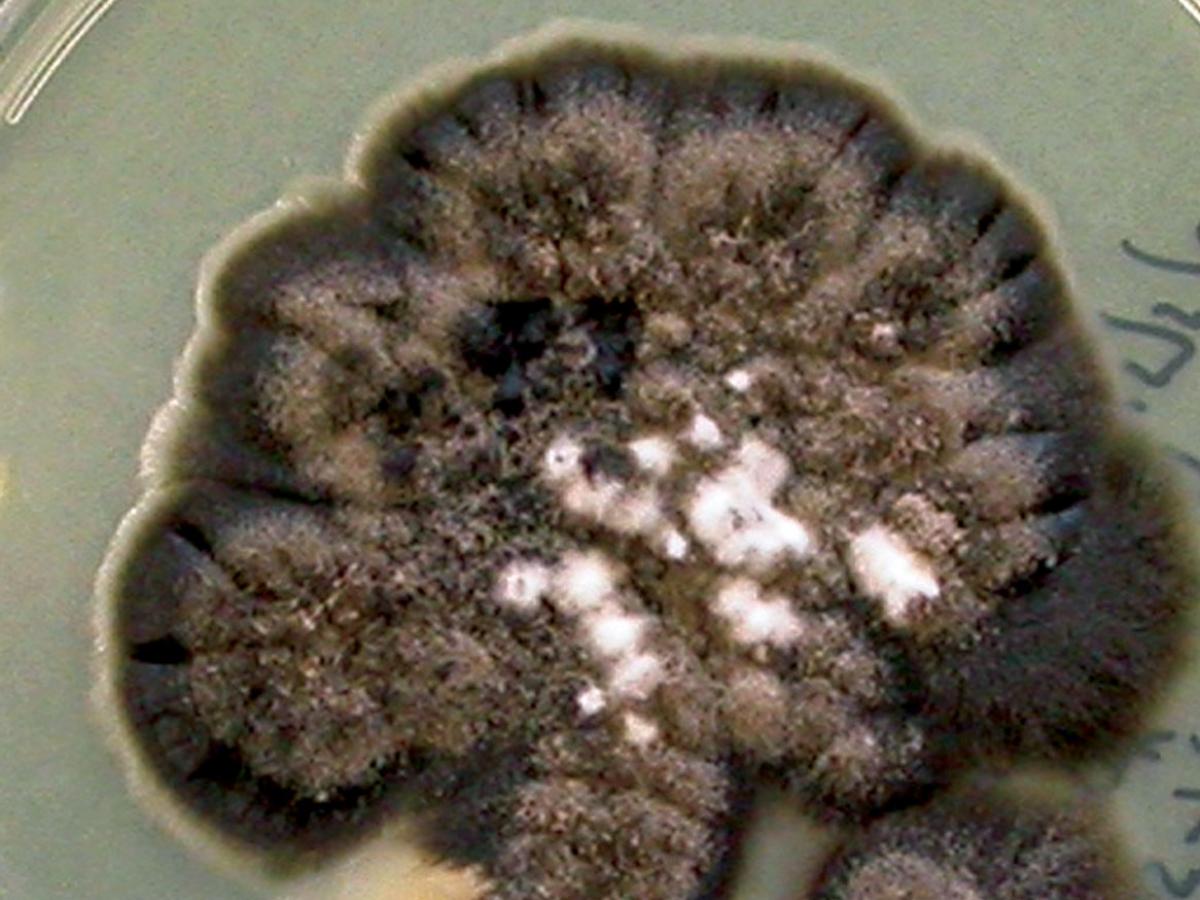
Culture

Status message
Correct! Excellent, you have really done well. Please find additional information below.
Unknown 33 = Sporothrix schenckii complex
Clinical appearance: Fixed cutaneous sporotrichosis showing an ulcerating lesion on the leg.

Histopathology (PAS stain): Section from a fixed cutaneous lesion with sporotrichosis showing round Periodic Acid-Schiff (PAS) positive yeast-like cells, one with an elongated bud. Sporothrix schenckii complex is a dimorphic fungus and this is the typical yeast-like form seen in tissue.

Culture: Sporothrix schenckii complex on Sabouraud's dextrose agar grown at 25C colonies are slow growing, moist and glabrous, with a wrinkled and folded surface. Some strains may produce short aerial hyphae and pigmentation may vary from white to cream to black.
Microscopy: Microscopic morphology of the saprophytic or mould form of Sporothrix schenckii complez when grown on Sabouraud's dextrose agar at 25C. Conidiophores arise at right angles from the thin septate hyphae and are usually solitary, erect and tapered towards the apex. Conidia are formed in clusters on tiny denticles by sympodial proliferation of the conidiophore, their arrangement often suggestive of a flower.

Microscopic morphology of the parasitic or yeast form of Sporothrix schenckii complex when grown on brain heart infusion agar containing blood and incubated at 37C. Note budding yeast cells are present.

Comment: Sporothrix schenckii complex has a world-wide distribution, particularly in tropical and temperate regions. It is commonly found in soil and on decaying vegetation and is a well-known pathogen of humans and animals.
Sporotrichosis is primarily a chronic mycotic infection of the cutaneous or subcutaneous tissues and adjacent lymphatics characterized by nodular lesions which may suppurate and ulcerate. Infections are caused by the traumatic implantation of the fungus into the skin, or very rarely, by inhalation into the lungs. Secondary spread to articular surfaces, bone and muscle is not infrequent, and the infection may also occasionally involve the central nervous system, lungs or genitourinary tract.
About Sporothrix Back to virtual assessment